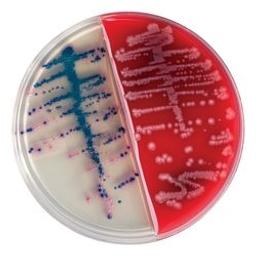
Bi-Plate BD BBL™ CHROMagar™ Orientation/BD BBL™ Trypticase™

Bi-Plate BD BBL™ CHROMagar™ Orientation/BD BBL™ Trypticase™ Soy Agar with 5% Sheep Blood Plate
BD has combined two products to formulate the BD BBL™ CHROMagar™ Orientation / TSA II I Plate™ for urine cultures. As today’s laboratories are challenged to do more with less, this format standardizes urine culture processing to a single catalog number. The I Plate allows for the visual identification of common urinary pathogens helping to improve turnaround time for positives.

The supplier does not provide quotations for this product through SelectScience. You can search for similar products in our Product Directory.
The BBL™ CHROMagar™ family of products utilize a chromogen mix that consists of artificial substrates (chromogens) that release differently colored compounds upon degradation by specific microbial enzymes, thus assuring the direct differentiation of certain species or the detection of certain groups of organisms with only a minimum of confirmatory tests.
BD BBL™ CHROMagar™ Orientation / TSA II I Plate
• Provides microbiology-standardized urine culture processing in a single plate.
• BD BBL™ CHROMagar™ Orientation side - A nonselective medium for use in the isolation, differentiation, and enumeration of urinary tract pathogens. Allows for differentiation and identification of E. coli and Enterococcus without confirmatory testing.
• BD BBL™ TSA II side – For use in the recovery and cultivation of fastidious microbial species.
• With both media formulations on one plate, laboratories can gain a presumptive ID and a culture for further confirmatory testing, saving space and reducing cost.
Note: Not all products are available in all geographies, please contact your local BD representative for product details, specs, or ordering information.